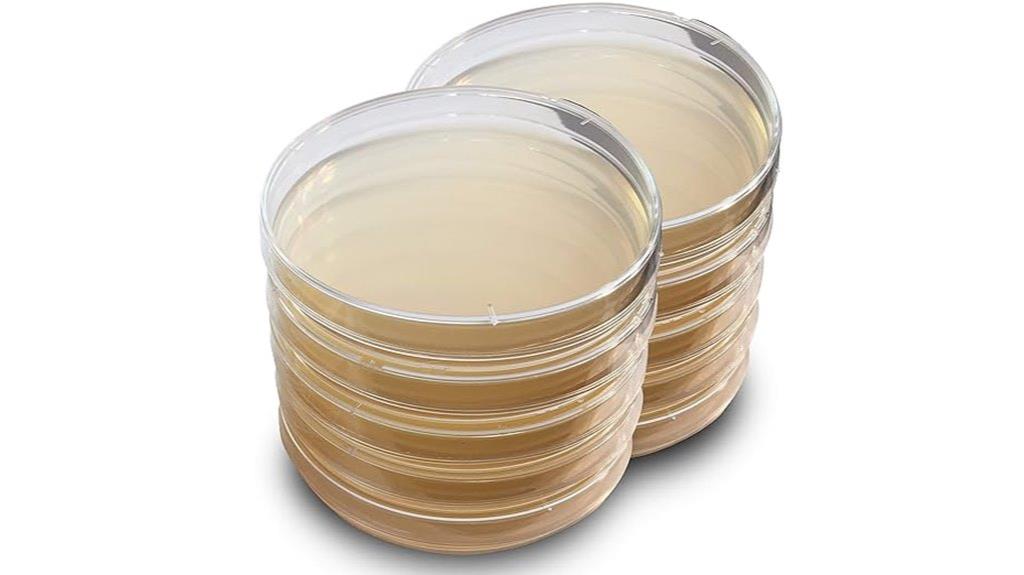
lb agar plates available

If you’re searching for the 14 best premium agar art kits for stunning creations in 2025, I’ve uncovered top options like high-quality agar powders, sterile petri dishes, and versatile fungal strains that make professional-looking edible and decorative designs. These kits combine safety, ease of use, and premium materials to help both beginners and experienced artists achieve amazing results. Keep exploring to discover the essential features and tips to choose the perfect kit for your creative projects.
Key Takeaways
- Premium agar art kits feature high-quality, plant-based agar mediums for vibrant, detailed edible microbe designs.
- They include pre-poured agar plates, specialized tools, and comprehensive instructions for stunning agar art creations.
- Top kits offer eco-friendly, vegan, and gluten-free options, ensuring safe, sustainable, and creative microbiology projects.
- Many kits provide vibrant color powders, dyes, and customization accessories to enhance visual effects and intricate designs.
- The best sets are designed for all skill levels, from beginners to advanced artists, with durable materials and expert support.
Ahakito Air Dry Clay Kit for Adults

Are you a beginner or hobbyist looking for a versatile, easy-to-use clay kit? The Ahakito Air Dry Clay Kit for Adults is perfect for you. It includes three 1.1-pound bags of soft, self-hardening clay that dries within 24-48 hours without cracking, no kiln needed. The kit provides all essential tools—sculpting tools, sponge, paints, and varnish—making it ideal for creating jewelry, decorations, or sculptures at home. It’s suitable for all ages, offering a relaxing, creative experience. Plus, with clear instructions and vibrant materials, you’ll enjoy transforming simple clay into beautiful, personalized pieces with ease.
Best For: Beginners and hobbyists of all ages seeking an easy, versatile, and creative clay-making experience at home.
Pros:
- Includes all necessary tools and supplies for a complete crafting experience
- Self-hardening clay dries within 24-48 hours without cracking or kiln firing
- Suitable for creating a variety of projects like jewelry, decorations, and sculptures
Cons:
- Limited to air drying; may not have the same durability as kiln-fired ceramics
- Requires space and time for the clay to fully dry and cure
- Some users may prefer additional colors or advanced tools for more detailed work
Bacteria Science Kit (IV): Science Fair Project Kit with LB-Agar Plates and Cotton Swabs

The Bacteria Science Kit (IV) is an excellent choice for students and educators seeking a reliable, safe way to explore microbiology through hands-on experiments. It includes fresh, factory-direct LB-agar plates and cotton swabs, all manufactured in the USA to high biotech GMP standards. The plates feature a thick agar layer that encourages faster bacterial growth, and the re-sealable packaging makes reuse easy. Designed for safety and ease of use, the kit is perfect for classroom or home experiments. Plus, it comes with a free science fair project e-book filled with clear, tested instructions, boosting confidence and success in microbiology projects.
Best For: students, educators, and homeschooling parents looking for a safe, reliable microbiology experiment kit for educational and science fair projects.
Pros:
- Includes fresh, factory-direct LB-agar plates with a thick agar layer for faster bacterial growth.
- Manufactured in the USA following biotech GMP standards, ensuring high quality and safety.
- Comes with a free, easy-to-follow science fair project e-book and live expert support for successful experiments.
Cons:
- Limited to 10 agar plates and 10 cotton swabs, which may require additional supplies for extensive projects.
- Re-sealable packaging, while convenient, may wear out over multiple uses if not handled carefully.
- The kit is primarily designed for educational use and may not be suitable for advanced microbiological research.
Bacteria Science Kit with Petri Dishes and Swabs

If you’re looking for an engaging way to introduce kids to microbiology, the Bacteria Science Kit with Petri Dishes and Swabs is an excellent choice. It offers a hands-on experience with 10 pre-poured LB-agar plates, sterile swabs, and droppers, along with an easy-to-follow guide. Designed for children aged 6-12, it makes bacterial growth experiments safe and accessible. The kit is compact and user-friendly, perfect for budding scientists. With positive reviews and a top spot in educational science kits, it’s a fun, educational tool that sparks curiosity and encourages exploration of the microscopic world.
Best For: young science enthusiasts aged 6-12 interested in exploring microbiology through safe, hands-on experiments.
Pros:
- Complete kit with pre-poured agar plates and sterile supplies for easy setup
- Educational and engaging, ideal for young learners to develop scientific curiosity
- Compact and user-friendly design makes it suitable for home or classroom use
Cons:
- Limited to bacterial growth experiments without additional advanced microbiology tools
- Requires adult supervision for safe handling of bacterial samples
- May need additional materials or experiments for more in-depth microbiology exploration
Bacteria Science Kit (IV) Gift Pack with LB-Agar Plates and Cotton Swabs

This Bacteria Science Kit (IV) Gift Pack is perfect for students and hobbyists enthusiastic to explore microbiology safely at home or school. It includes 10 pre-poured LB-Agar plates made in the USA, offering a fresh, thick layer that encourages rapid bacterial growth. The kit also features 10 sterile cotton swabs stored in resealable pouches for easy, repeat use. Designed with safety in mind, these plates detect environmental microorganisms worldwide, making them ideal for educational experiments. Plus, a free science fair e-book provides clear instructions and tips for successful projects. Support from PhD scientists and a solid 4.4-star rating make this kit a reliable choice for budding microbiologists.
Best For: students, educators, and hobbyists interested in safe, hands-on microbiology experiments at home or school.
Pros:
- Includes pre-poured LB-Agar plates and sterile cotton swabs for immediate use, ensuring convenience and safety.
- Comes with a free science fair e-book with clear instructions, making it easy for beginners to succeed.
- Manufactured in the USA to high biotech GMP standards, guaranteeing product quality and safety.
Cons:
- Limited to educational and hobbyist use; not suitable for clinical or medical microbiology applications.
- Requires basic knowledge of microbiology safety protocols to prevent contamination or accidents.
- The product’s rating, while generally good, indicates some users may experience issues with packaging or results.
Evviva Sciences Microbiology Science Project Kit

Designed for teenagers and adult science enthusiasts, the Evviva Sciences Microbiology Science Project Kit offers a straightforward way to explore microbiology without the need for complex equipment. It includes 10 pre-poured agar plates, cotton-tipped sticks, a pipette, and an educational ebook, making setup simple and accessible. The thick agar layers guarantee reliable results, while the ready-to-use design removes the need for melting and pouring. This kit encourages hands-on learning by allowing you to test bacterial presence on surfaces like phones and door handles or verify sterilization methods. Its user-friendly setup and detailed instructions make it ideal for classroom projects, science fairs, or home experimentation.
Best For: teenagers and adult science enthusiasts interested in hands-on microbiology experiments and educational projects.
Pros:
- Includes all necessary materials for immediate use, simplifying setup.
- Promotes engaging, educational exploration of microbiology techniques.
- Durable packaging and high-quality agar plates ensure reliable, repeatable results.
Cons:
- Some users report initial moisture or contamination issues with plates.
- Limited to basic microbiology experiments without advanced lab equipment.
- Requires careful sterile technique to prevent cross-contamination during experiments.
anlab Nutrient Agar Petri Dishes Science Project Kit

The anlab Nutrient Agar Petri Dishes Science Project Kit is an excellent choice for educators and students seeking a reliable, easy-to-use microbiology experiment set. It includes 10 pre-poured agar plates and 10 individually sealed cotton swabs, ensuring freshness and preventing contamination. If plates arrive melted, refrigerate them for half an hour before use. The kit also provides pipettes, vials, and clear instructions, making it perfect for classroom and fair projects. Its individual packaging allows selective use, reducing waste. Plus, damaged plates are easily replaced. Overall, this kit offers convenience, safety, and versatility for a variety of microbiology experiments.
Best For: educators, students, and science enthusiasts seeking a safe, convenient, and reliable microbiology experiment kit for classroom and fair projects.
Pros:
- Individually sealed plates and swabs ensure freshness and reduce contamination risk.
- Complete kit includes all necessary tools like pipettes, vials, and instructions for easy use.
- Re-sealable damaged plates and separate packaging extend shelf life and minimize waste.
Cons:
- Plates arriving melted require refrigeration before use, which may delay experiments.
- Cannot identify mold types, only detects its presence.
- Limited to microbiology experiments and not suitable for advanced or medical-grade research.
ES EVVIVA SCIENCES Agar Variety Kit

If you’re passionate about mycology, research, or educational projects, the ES EVVIVA SCIENCES Agar Variety Kit offers a versatile set of prepared plates that make cultivating fungi straightforward. It includes three formulations: Black Dye & Charcoal Mix PDA, standard PDA for mushroom cultivation, and MEA for mycelium growth. These plates are perfect for science experiments, mold detection, or mushroom growing. They arrive sterile and well-packaged, supporting effective fungal cultures. While some plates may be slightly overfilled, customer support is helpful and responsive. Overall, this kit provides high-quality media, making it a reliable choice for both beginners and experienced mycologists.
Best For: hobbyists, students, and researchers interested in mycology, mold detection, or mushroom cultivation seeking high-quality, prepared agar media for educational or research purposes.
Pros:
- Includes three versatile formulations suitable for various fungal studies and cultivation.
- Sterile, high-quality plates arrive well-packaged, ensuring reliable results.
- User-friendly for both beginners and experienced mycologists with responsive customer support.
Cons:
- Some plates may be slightly overfilled, making handling more challenging.
- Lack of printed type identification on some plates can complicate tracking.
- Not intended for food, drug, or medical use, limiting application scope outside research and education.
Evviva Sciences Nutrient Agar Petri Dishes Science Project Kit

The Evviva Sciences Nutrient Agar Petri Dishes Science Project Kit is an excellent choice for educators, parents, and students aged 13 and older who want a straightforward introduction to microbiology. It includes 10 pre-poured agar plates, cotton-tipped sticks, instructions, and an experiment eBook, making setup simple. The plates are ready to use, with a thick agar layer that guarantees consistent results. This kit allows users to swab surfaces like soil, food, or shoes and observe microbial growth easily. Its clear instructions and durable packaging support engaging, educational experiments, fostering curiosity and hands-on learning in microbiology.
Best For: educators, parents, and students aged 13 and older seeking an easy, educational microbiology experiment kit.
Pros:
- Pre-poured agar plates for quick, mess-free setup
- Clear instructions and experiment eBook support learning and safety
- Durable packaging and ready-to-use plates ensure consistent results
Cons:
- Some plates may arrive contaminated with mold or develop mold during storage
- Not suitable for advanced microbiology or professional research
- Limited to basic microbiology activities, which may not satisfy more experienced users
120 Pcs Microbiology Agar Plates Kit (Petri Dishes, Swabs, Pipettes, Cryotubes)

Looking to introduce beginners to microbiology or spark curiosity in young scientists? The Pcs Microbiology Agar Plates Kit is perfect for hands-on exploration. It includes 40 prefilled agar petri dishes, 40 cotton swabs, 20 pipettes, and 20 cryotubes—everything needed for immediate experiments. The petri dishes are durable, with tight-fitting lids to prevent contamination, and the kit is easy to handle. Designed for learners of all ages, it promotes discovery and understanding of microbial growth, making it ideal for home labs, classrooms, or science fairs. This all-inclusive kit makes microbiology accessible, fun, and educational for aspiring scientists.
Best For: beginners, educators, and young aspiring scientists interested in microbiology experiments at home or in classroom settings.
Pros:
- Complete all-in-one kit with petri dishes, swabs, pipettes, and cryotubes for immediate use
- Durable, quality plastic materials with tight-fitting lids to prevent contamination
- Promotes hands-on learning and curiosity about microbiology in a fun and educational way
Cons:
- Customer reviews average only 3.1 stars, indicating mixed satisfaction
- Slight size variations due to manual measurement and potential color differences from screens
- Limited to ages 14+ and may require adult supervision for younger users
Malt Extract Agar (MEA) Plates for Mushroom Cultivation

Are you searching for a reliable, ready-to-use medium to cultivate mushrooms and other fungi? EZ BioResearch’s Malt Extract Agar (MEA) Plates are perfect for this. Made with high-quality Malt Extract, Peptone, Dextrose, and Agar, they support healthy fungal growth, including yeasts, molds, and mushrooms. These plates come pre-poured with a thick, smooth surface, eliminating the hassle of preparation. Their consistent quality and clarity are guaranteed thanks to industrial manufacturing, ensuring reliable results every time. Whether for microbiology research, education, or mushroom cultivation, these MEA plates are an efficient, user-friendly choice that helps you achieve stunning fungal growth with ease.
Best For: hobbyist and professional mycologists, educators, and researchers seeking a reliable, ready-to-use medium for cultivating mushrooms, molds, and fungi with ease and consistency.
Pros:
- Pre-poured with a thick, smooth agar surface for convenience and ease of use
- Made with high-quality ingredients supporting robust fungal growth
- Industrial manufacturing ensures consistent quality and batch reliability
Cons:
- Limited to fungal cultivation and not suitable for bacterial growth
- May be more expensive than homemade media options
- Requires careful handling to prevent contamination after opening
LB Agar Plates – Evviva Sciences
Pre-poured LB agar plates from Evviva Sciences are an excellent choice for students and educators seeking a reliable, ready-to-use medium for classroom experiments and science fairs. These plates support bacterial growth effectively, making them perfect for educational projects. They arrive in excellent condition, with a thick agar layer that resists drying and cracking, ensuring consistent results. The pre-poured format saves time and reduces mess, allowing you to focus on your experiments. While not intended for medical or food use, they’re ideal for learning and research purposes. Evviva Sciences stands behind their quality, offering replacements if plates arrive damaged, ensuring your project runs smoothly.
Best For: students, educators, and hobbyists seeking a reliable, ready-to-use medium for classroom experiments and science fairs involving bacterial growth.
Pros:
- Convenient pre-poured format saves time and reduces mess
- Supports bacterial growth effectively for educational projects
- Arrives in excellent condition with a durable agar layer
Cons:
- Not suitable for medical, food, or pharmaceutical applications
- No sterility guarantee beyond educational use
- Does not include a Certificate of Analysis
Hoosier Hill Farm Agar Agar Powder, 1LB (Pack of 1)

Hoosier Hill Farm Agar Agar Powder is an excellent choice for anyone interested in creating vibrant, edible art with agar-based mediums. This natural, vegan, plant-based thickener comes from red algae and works as a versatile substitute for gelatin. It produces a firm, gummier texture and sets quickly at room temperature, making it perfect for molded creations like panna cotta or gummies. With a higher potency than gelatin—just one teaspoon equals 2-3 teaspoons of gelatin—you’ll need to adjust recipes accordingly. Packaged in a 1-pound size, it’s ideal for both small projects and larger art pieces. Store it in a cool, dry place for best results.
Best For: vegans, home cooks, and artists seeking a versatile, plant-based thickener for culinary and creative projects.
Pros:
- Natural, vegan, and plant-based from red algae, suitable for vegans and vegetarians.
- Sets quickly at room temperature with a firm, gummier texture ideal for molds and gummies.
- More potent than gelatin, allowing for smaller quantities and efficient thickening.
Cons:
- Requires careful measurement and adjustment due to higher potency compared to gelatin.
- Should not be refrigerated or frozen, which may be inconvenient for storage.
- Packaged in a facility processing potential allergens like dairy, soy, peanuts, and wheat, posing risks for allergy-sensitive individuals.
Aldon Laboratory-Grade Agar Powder (100g)

If you’re looking for a reliable foundation for microbiology experiments or educational projects, Aldon Laboratory-Grade Agar Powder (100g) stands out as an excellent choice. This high-quality, powdered medium is made in the USA and is part of The Curated Chemical Collection. It’s perfect for preparing culture media like Nutrient Agar or Tryptic Soy Agar. The powder itself contains no nutrients, so you’ll add your own ingredients to support microbial growth. Easy to prepare—just mix with water, boil, and pour into petri dishes or tubes—it’s ideal for classrooms and labs. Its consistent quality guarantees reliable results every time.
Best For: microbiology students, educators, and researchers seeking a reliable, high-quality agar powder for preparing culture media in laboratory and educational settings.
Pros:
- Easy to prepare by mixing with water and boiling for straightforward use.
- Manufactured in the USA, ensuring high quality and consistency.
- Versatile for creating various culture media like Nutrient Agar or Tryptic Soy Agar.
Cons:
- Contains no nutrients itself; requires additional ingredients to support microbial growth.
- Needs to be sterilized before use to prevent contamination.
- May not be suitable for experiments requiring specific nutritional formulations without supplementation.
Bacteria Science Kit with LB Agar Plates and Cotton Swabs

The Bacteria Science Kit with LB Agar Plates and Cotton Swabs is perfect for students, educators, and science enthusiasts who want a reliable, safe, and educational microbiology experience. The kit includes 10 fresh, sterile LB agar plates made in the USA, providing a nutrient-rich environment for rapid bacterial growth. It also features sterile cotton swabs, transfer pipets, and dilution tubes for accurate sampling and transfer. The re-sealable packaging allows for reuse, and the included science fair e-book offers easy, guided experiments to boost learning. This all-encompassing, high-quality kit makes microbiology experiments accessible, safe, and engaging for all levels of science exploration.
Best For: students, educators, and science enthusiasts seeking a reliable, safe, and educational microbiology experiment kit for classroom, home, or science fair projects.
Pros:
- Includes fresh, sterile LB agar plates manufactured in the USA following GMP standards, ensuring consistent quality and safety.
- Contains all necessary tools, such as sterile cotton swabs, transfer pipets, and dilution tubes, for accurate sampling and transfer.
- Comes with a free science fair project e-book offering easy-to-follow, scientifically designed experiments to enhance learning and success.
Cons:
- Limited to 10 agar plates, which may not be sufficient for very large class projects or extensive experiments.
- Requires additional materials or equipment (like incubators) not included in the kit for bacterial growth.
- Designed primarily for educational use; may not be suitable for advanced microbiological research or professional laboratory applications.
Factors to Consider When Choosing a Premium Agar Art Kit

When selecting a premium agar art kit, I look closely at the quality of the agar medium, since it directly affects my results. I also consider the variety of fungal strains included and how easy the packaging is to store and keep sterile. Ensuring compatibility with different cultures and minimizing contamination risks are vital factors I keep in mind.
Quality of Agar Medium
Choosing a premium agar art kit starts with evaluating the quality of the agar medium itself. The nutrient composition, clarity, and consistency are key factors that directly influence microbial growth and the quality of your artwork. High-quality agar should have a smooth, uniform surface free of cracks, bubbles, or contamination, which ensures reliable and clean designs. The thickness of the agar layer also matters; thicker plates offer a sturdier surface for detailed work and durability. Additionally, sourcing from reputable manufacturers guarantees purity and sterility, supporting diverse microbial growth for vibrant results. Freshly poured, well-prepared agar promotes faster growth and more vivid, long-lasting designs. Overall, investing in top-quality agar sets a solid foundation for stunning agar art creations.
Variety of Fungal Strains
A variety of fungal strains included in an agar art kit considerably expands your creative possibilities by offering diverse colors, textures, and growth patterns. Different strains have unique appearances and growth requirements, which can influence your project’s success and visual effects. Incorporating molds, yeasts, and other fungi allows for a broad spectrum of artistic effects, from vibrant hues to intricate textures. Choosing strains with known compatibility for agar guarantees reliable growth and predictable results, making your artistic process smoother. Understanding the specific strains included helps you select a kit that balances safety with a wide range of fungal diversity. This variety not only enhances your creative options but also provides a richer educational experience, making each project more engaging and visually striking.
Packaging and Storage Ease
Selecting a premium agar art kit with thoughtful packaging can make a significant difference in your creative process. Resealable packaging helps keep the agar plates fresh and sterile over time, ensuring your work remains pristine. Kits with individually sealed plates and tools prevent contamination and allow you to use only what you need, reducing waste. Clear storage instructions, like refrigeration guidelines, help maintain agar viability and extend shelf life. Durability is also key—a sturdy, well-designed package protects your supplies during transport and handling. Additionally, easy-to-open containers simplify storage and minimize accidental spills or contamination risks. Overall, well-designed packaging not only safeguards your materials but also enhances your experience, making it easier to focus on your art without worrying about preservation or messes.
Sterility and Contamination Risks
When it comes to creating detailed agar art, maintaining sterility is vital to prevent contamination that can ruin your work. Using sterile tools and techniques guarantees microorganisms don’t interfere with your designs. Re-sealable or sealed packaging helps preserve the sterility of agar plates before use, reducing contamination risks. Proper storage in cool, dry environments keeps plates free from mold and bacteria, extending their shelf life. Handling agar plates with clean gloves and avoiding contact with non-sterile surfaces are essential steps to prevent unwanted microorganisms from contaminating your artwork. Additionally, choosing plates that are freshly prepared or properly stored minimizes the chances of mold spores or bacteria. Prioritizing these factors helps guarantee your agar art remains clean and free from contamination, resulting in more vibrant and precise creations.
Compatibility With Cultures
Have you checked if the agar medium in your kit is compatible with the specific microbial cultures you plan to use? Ensuring compatibility is vital for vibrant and healthy growth. You need to verify that the agar base provides the right nutrients and pH level tailored to your cultures, whether bacteria, fungi, or molds. Different organisms often require specialized media, like nutrient agar or malt extract agar, so matching the formulation to your microbes is necessary. Additionally, confirm that the kit includes or works with inoculation tools and supplements suited for your chosen organisms. Quality and sterility standards matter too, as they help prevent contamination and create ideal growth conditions. Taking these factors into account ensures your agar art project flourishes as intended.
Ease of Preparation
Choosing a premium agar art kit that’s easy to prepare can make a significant difference, especially if you’re new to the craft. Opt for kits with pre-poured plates to save time and minimize mess, so you can focus more on creating rather than cleaning. Look for clear, straightforward instructions that guide you step-by-step, which is essential when you’re just starting out. High-quality, professionally prepared agar layers that are thick and uniform provide a solid base for your artwork, ensuring consistent results. Additionally, sealed, sterile plates prevent contamination, making your process safer and more reliable. Finally, select kits with minimal preparation steps, such as ready-to-use plates, to streamline your experience and make creative exploration more accessible and enjoyable.
Price and Value
Evaluating the price and value of a premium agar art kit involves comparing the cost per unit of plates and tools to guarantee you’re getting a fair deal for what’s included. I look at whether the kit provides all necessary supplies, like different types of agar, swabs, and tools, to maximize its overall worth. Higher-priced kits often include better quality agar, more durable tools, or extra educational resources, which can be beneficial long-term. I also consider user reviews and ratings to gauge real-world value and satisfaction. It’s important to balance the price with the versatility and educational potential of the kit, ensuring it meets my needs without paying extra for unnecessary items. This approach helps me find a kit that offers both quality and good value.
Frequently Asked Questions
What Safety Precautions Are Necessary for Using Premium Agar Art Kits?
When using premium agar art kits, I always wear gloves and a mask to avoid inhaling spores or getting ink in my eyes. I make sure my workspace is clean and well-ventilated, and I follow the instructions carefully to prevent contamination. I also wash my hands thoroughly after each session. Safety is key to enjoying the process and creating stunning, healthy artwork without any risks.
Can These Kits Be Used for Educational Purposes at Home?
Absolutely, these kits serve as a gateway to learning at home. Think of them as a bridge connecting curiosity to creativity, illuminating scientific principles through art. I’ve used them with my kids to teach about microbiology and color blending, making education engaging and hands-on. They’re perfect for sparking interest in science, fostering patience, and exploring artistic expression—all within a safe, manageable environment at home.
How Long Does It Typically Take to See Results With These Kits?
You’ll usually see results within a few days to a week after starting your agar art project. It depends on the complexity of your design and the growth rate of the fungi or bacteria involved. I recommend being patient and following the kit’s instructions carefully. Keep your work in a warm, dark place, and you’ll be amazed at how quickly your stunning creations come to life!
Are There Specific Tools Recommended for Creating Detailed Agar Art?
When it comes to creating detailed agar art, I swear by fine-tipped tweezers and precision pipettes. They’re like the artist’s brush and pencil—allowing me to add tiny, intricate details with ease. I also use small, sharp needles to carve delicate lines. These tools help me bring my visions to life, transforming simple agar into stunning, detailed masterpieces that truly stand out.
What Is the Shelf Life of Unopened Agar Art Kits?
Unopened agar art kits typically last around one to two years when stored properly in a cool, dry place. I always check the expiration date on the packaging, as it can vary between brands. Proper storage is key to keeping the ingredients fresh and ensuring your kits are ready when inspiration strikes. If the date has passed, I recommend replacing the kit to guarantee the best results for your art projects.
Conclusion
Choosing the right agar art kit is like opening a world of endless possibilities, where each plate becomes a canvas and every creation a reflection of your imagination. These kits are more than tools—they’re gateways to discovery, moments of wonder, and the spark that ignites your passion for science and art. Embrace this journey, and let your curiosity blossom into stunning masterpieces that inspire and captivate. Your next extraordinary creation awaits—dare to bring it to life.









